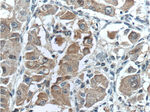
ARG1 Antibody in Immunohistochemistry (Paraffin) (IHC (P))

Search
Proteintech
ARG1 Monoclonal Antibody (5D6D12)
{{$productOrderCtrl.translations['antibody.pdp.commerceCard.promotion.promotions']}}
{{$productOrderCtrl.translations['antibody.pdp.commerceCard.promotion.viewpromo']}}
{{$productOrderCtrl.translations['antibody.pdp.commerceCard.promotion.promocode']}}: {{promo.promoCode}} {{promo.promoTitle}} {{promo.promoDescription}}. {{$productOrderCtrl.translations['antibody.pdp.commerceCard.promotion.learnmore']}}

Please note: We are reviewing Western blot images included in the antibody testing data in our catalog, including those provided by third parties. Unless expressly labeled or annotated as “raw-unedited”, Western blot images included in the antibody testing data in our catalog may have been edited, optimized or otherwise adjusted for presentation.
产品信息
66129-1-IG
种属反应
已发表种属
宿主/亚型
分类
类型
克隆号
抗原
偶联物
形式
浓度
规格
纯化类型
保存液
内含物
保存条件
运输条件
产品详细信息
Immunogen sequence: MSAKSRTIG IIGAPFSKGQ PRGGVEEGPT VLRKAGLLEK LKEQECDVKD YGDLPFADIP NDSPFQIVKN PRSVGKASEQ LAGKVAEVKK NGRISLVLGG DHSLAIGSIS GHARVHPDLG VIWVDAHTDI NTPLTTTSGN LHGQPVSFLL KELKGKIPDV PGFSWVTPCI SAKDIVYIGL RDVDPGEHYI LKTLGIKYFS MTEVTRTVNT AVAITLACFG LAREGNHKPI DYLNPPK (1-236 aa encoded by BC005321)
靶标信息
Arginase-1 (Arg1) is a 35 kDa enzyme converting L-arginine to urea and L-ornithine, which is the final step in the urea cycle. The resulting polyamines are important for cell proliferation and removal of toxins that arise from protein degradation. By degrading arginine, Arginase 1 deprives NO synthase of its substrate and down-regulates nitric oxide production. In both human and mouse, Arginase 1 is expressed in the liver, neutrophils, myeloid derived suppressor cells (MDSC) and neural stem cells. In human, expression in blood neutrophils but not in CCR3+ granulocytes has been reported. In mice, expression of Arginase 1 is one of the hallmarks of alternatively activated macrophages (M2a). Arginase-1 may be expressed in the myeloid cells infiltrating tumors, and is typically found in the majority of hepatocellular carcinomas. Defects in Arginase 1 are the cause of argininemia, an autosomal recessive disorder characterized by hyperammonemia.
仅用于科研。不用于诊断过程。未经明确授权不得转售。
生物信息学
蛋白别名: A-I; AI type I arginase; Arginase; arginase 1 liver; arginase 1, liver; arginase I; arginase, liver; Arginase-1; Arginase1; HGNC:663; Liver Arginase; Liver-type arginase; Type 1 Arginase; Type I arginase
基因别名: AI; AI256583; Arg-1; ARG1; PGIF
UniProt ID: (Pig) Q95JC8, (Rat) P07824, (Mouse) Q61176
Entrez Gene ID: (Pig) 397115, (Rat) 29221, (Mouse) 11846




